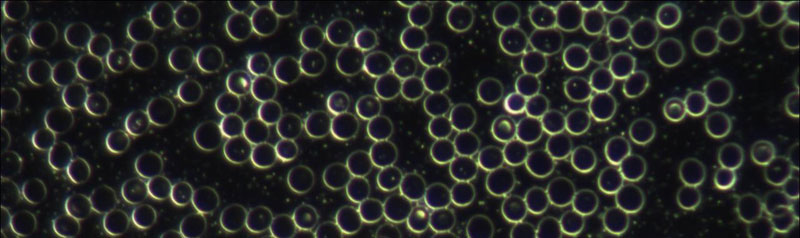

Anamnesegespräch:
Das Gespräch ist der zentrale Ausgangspunkt jeglicher Therapieentscheidung! Gemeinsam versuchen wir die Ursachen der Beschwerden zu finden, um eine optimale Behandlung festzulegen. Deshalb nehme ich mir in der Diagnostik für Sie Zeit und ein ausgiebiges Gespräch ist mir wichtig!
Klassische Untersuchung:
Im Sinne des ganzheitlichen Ansatzes ist es von Bedeutung, sich zuerst einen allgemeinen Eindruck vom körperlichen und seelischen Zustand des Patienten zu verschaffen. Einzelne Bestandteile der klassischen Untersuchung untermauern diesen Befund, zum Beispiel die Blutdruck- und Pulsmessung, körperliche Untersuchung und eventuell Stuhl-, Urin- bzw. Laborbefundung.
Applied Kinesiologie:
Ausgehend von der entspannten Rückenlage werden verschiedene Muskeln einem organspezifischen Belastungstest unterzogen. Damit kann eine Aussage über die Leistungsfähigkeit der jeweiligen Organe getroffen werden. So ist es möglich, Unverträglichkeiten, Allergien oder Mangelzustände zu diagnostizieren. Ebenso können Störfelder wie Piercings, Entzündungen an Zähnen oder Narben ermittelt werden.
Dunkelfelddiagnostik:
Ein Tropfen Blut wird aus der Fingerbeere oder dem Ohrläppchen entnommen und sofort unter einem speziellen Mikroskop untersucht. Die Besonderheit dieses Verfahrens besteht darin, dass das Blut in seinem vitalen Zustand analysiert wird. Dieser Istzustand gibt Hinweise sowohl für die Vorbeugung als auch für die Behandlung von akuten oder chronischen Erkrankungen.